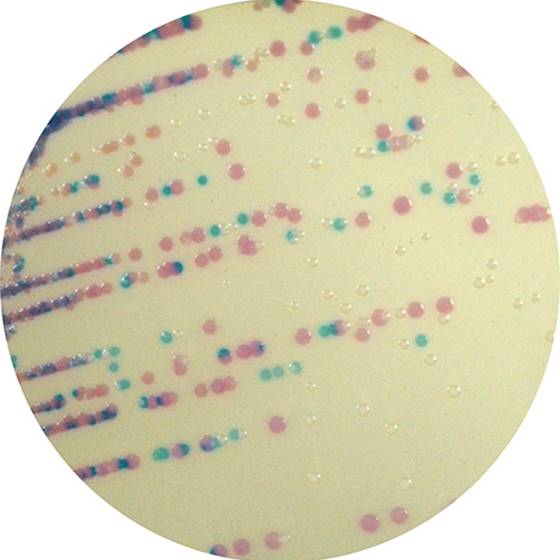

Über das Produkt
Chromogenes Medium zur Isolierung und Differenzierung von Staphylococcus spp. aus Industrieprodukten sowie Veterinär- und Umweltproben.
Ähnliche Produkte
CHROMagar Staphylococcus (5L) - ohne CE
CHROMagar MRSA/CHROMagar Staph.aureus /Fertigpl.
CHROMagar MRSA Fertigplatten
CHROMagar MRSA (5L)